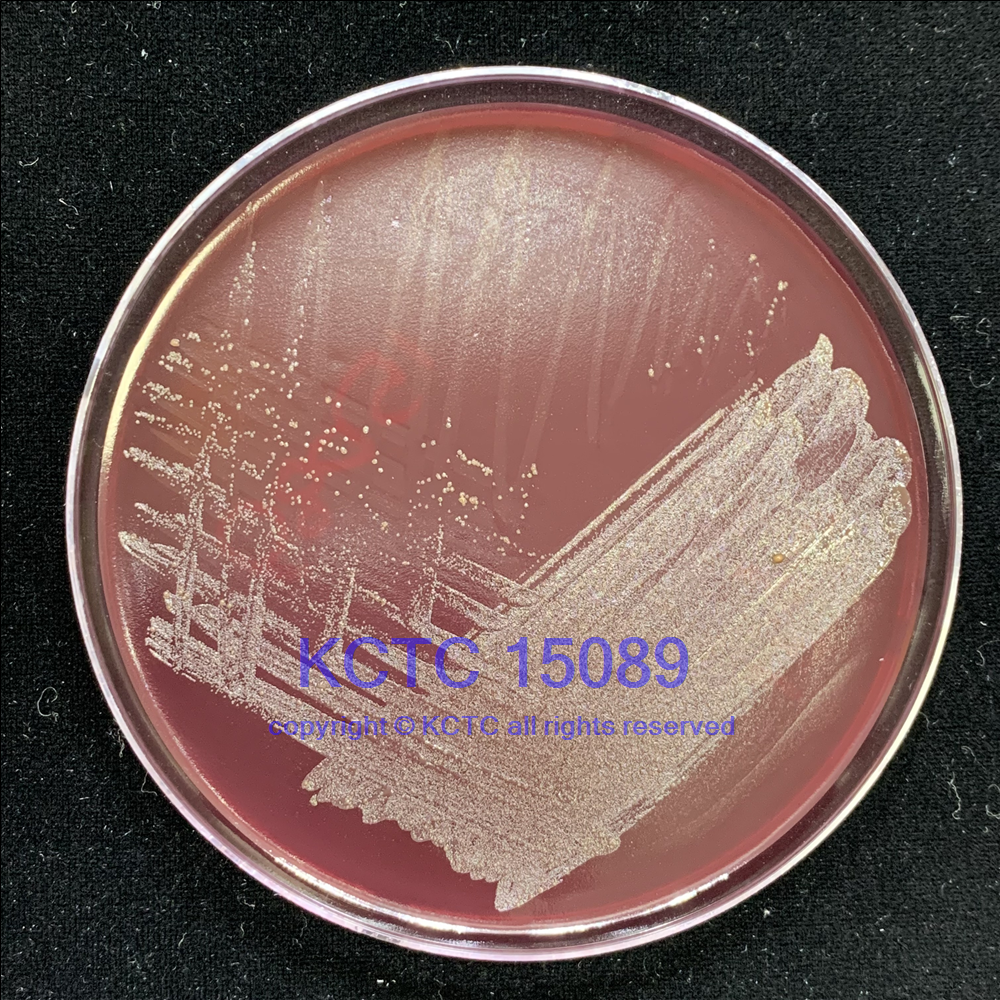

產(chǎn)品名稱:犬齒齦液卟啉單胞菌
拉丁名:Porphyromonas cangingivalis
來(lái)源編號(hào):=ATCC 700135
AHN 4309, VPB 4874, ATCC [700135], CCUG [47700], DSM [104739], JCM [13862], JCM [15983], NCTC [12856] KCTC 15089
培養(yǎng)基:碎肉碳水化合物肉湯(CMC)/巧克力血瓊脂
培養(yǎng)條件:37°C厭氧環(huán)境下培養(yǎng)
培養(yǎng)時(shí)間:48-72小時(shí)